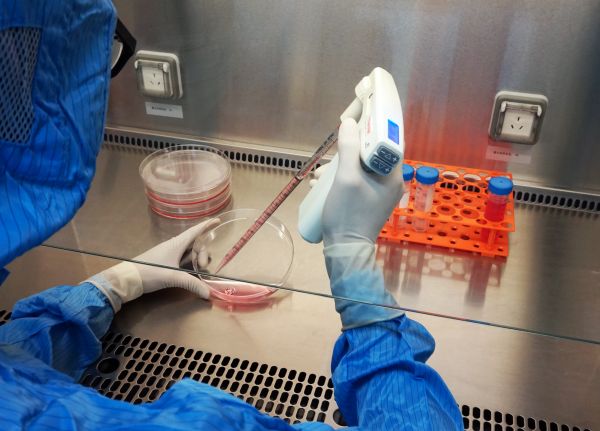

风口上的细胞外囊泡免疫疗法实现临床转化:「盛齐安」DTMI技术湖北多癌种物价获批
针对已明确疗效和安全性的重大疾病治疗技术,中国正在加快市场准入的审批速度。
日前,湖北省医保局和卫健委下发《关于部分新增和修订医疗服务价格项目有关问题的通知》,通过一批新增医疗服务项目的审批,其中,载药囊泡治疗肿瘤技术针对多癌种适应症也正式获批,可在更多适应症开展临床应用。
这也意味着,中国首创载药囊泡治疗肿瘤技术的应用市场和人群扩容,让更多患者获益。
兼具免疫治疗和生物化疗特性的新疗法?
载药囊泡治疗肿瘤技术(drug-loaded tumor microparticle immunotherapeutics,以下简称“DTMI技术”)是一种以细胞外囊泡(EVs)为基础的全新肿瘤生物免疫治疗生物技术平台。
它以直径介于100-1000纳米之间的天然生物来源的细胞外囊泡为基础,与递送的药物分子或生物活性物质结合,形成全新的药物递送和控释模式,形成具有多种抗肿瘤功能的载药囊泡,通过动员数量最为庞大的、具有人体天然屏障之称的中性粒细胞达到治疗肿瘤的目的,是一种兼具免疫治疗和生物化疗特性的全新肿瘤免疫疗法。
而此次获批的DTMI技术由湖北盛齐安生物科技股份有限公司(Soundny-bio,870592,NEEQ)自主研发首创,拥有全球专利体系。
据介绍,区别于其他免疫疗法,DTMI技术利用囊泡在细胞间信息传递的特性,通过生物物理学的作用机理,其更易于靶向杀伤导致肿瘤复发和转移的肿瘤干细胞,同时激活免疫,重塑肿瘤免疫微环境,具有低毒、高效的特点。
截至目前,盛齐安生物与全国60余家主流三甲医院开展临床合作,目前已上市适应症包括恶性胸腔积液和胆管癌,即将上市适应症包括肺癌、胃癌、肝癌、食管癌、恶性腹腔积液等。

企业供图
布局恶性胸腔积液治疗的蓝海市场
值得关注的是,在已上市使用的适应症上,恶性胸腔积液被率先应用,这一市场被业内视为蓝海市场。
这是因为,肺癌、乳腺癌、卵巢癌等众多实体瘤均可转移至胸膜腔,形成恶性胸腔积液。仅以肺癌为例,高达60%晚期肺癌患者会出现恶性胸腔积液,严重影响患者的生存周期及生活质量,然而临床却缺乏有效治疗手段。
恒州博智信息咨询对外公布的一份《胸腔积液治疗市场分析报告》中显示,近几年来,全球胸腔积液治疗市场发展迅速,其中,2018年全球收入接近42.3亿美元,2019年为44.82亿美元,市场平均增长率为5.91%,预计2020-2026年复合年增长率为6.60%。
但目前,国内恶性胸腔积液的治疗尚无通用化的金标准,现有治疗手段大都以对症和姑息治疗为主。
而DTMI技术前期得多项临床研究结果显示,它已表现出良好的有效性和安全性,对比传统恶性胸腔积液治疗约50%左右的缓解率,DTMI技术的缓解率高出30%左右。
目前在全球范围内,针对以DTMI技术为代表的细胞外囊泡对疾病的治疗,已有多项研究展开。有一组基于PubMed检索的EVs统计显示,自2010年起,全球关于EVs的学术成果年均呈几何倍数增长。
资本市场上,包括腾讯、IIIumina等国内外知名机构纷纷提前布局细胞外囊泡领域,后者已成投资机构热烈追逐的蓝海市场。值得关注的是,这些项目的临床转化大都发展到临床前和临床1期阶段,与盛齐安生物的研发进度存在较为明显的差异。
11年的漫长研发
36氪了解到,关于DTMI技术的研发,最早可回溯到2009年,盛齐安生物研发团队在当时就开展了载药囊泡在肿瘤治疗中的研究,通过将化疗药物包裹于肿瘤细胞所释放的囊泡,证明了载药囊泡能够高效杀伤肿瘤细胞,该工作于2012年发表在《Nature Communications》。
紧接着,团队又进一步证实载药囊泡优先杀伤耐药的肿瘤种子细胞,相关结果发表在《Cell Research》、《Biomaterials》等刊物。彼时,国际上针对细胞外囊泡的基础研究都比较少。
企业供图
经过十余年的研究,该研发团队已先后阐明了囊泡与化疗药物、溶瘤病毒、生物大分子等有机结合,形成丰富的应用场景,并持续研究该技术对肿瘤细胞杀伤和作用机制,便于基础研究和临床专家不断优化临床治疗方案。
在技术未来的临床应用上,盛齐安生物总裁孟凡帆指出,该技术具有广谱的适应症,可以和化疗药物结合,也可以和病毒结合,也可以做疫苗相关研究,“它的适应症不光在肿瘤领域,我们将它定位为一个生物技术平台,具有广泛的应用场景”。
“医疗新技术模式”完成临床转化
值得一提的是,与一般经由NMPA获批上市的创新疗法不同,DTMI技术通过一种更“特殊”的“医疗新技术模式”完成了临床转化。
具体来说,医疗新技术模式为企业与医院签订医疗技术服务合同,由医院进行临床应用,符合当下和未来中国深化医药卫生体制改革的方向和趋势。
反映到公司的临床转化上,截至目前,该技术已获批在安徽、湖北、湖南、河北、天津、山东、深圳7省市上市使用,盛齐安生物也成为政策鼓励下的最早完成重大疾病攻关临床转化的医疗新技术公司之一。
据盛齐安生物董事、副总裁马刚介绍,在2019年下半年,该技术在安徽实现了首次收费,形成商业模式的闭环;随着该技术获得湖北省物价批件,并取得武汉协和医院的临床应用伦理批件,基于其庞大的患者数量,这也将是公司近期的销售重点。
36氪也了解到,盛齐安生物已于2017年2月在新三板挂牌。基于盛齐安生物所处的行业和拥有强科创属性,孟凡帆透露,目前已有很多机构和主办券商主动寻求合作,公司会考虑企业的发展节奏,在适当的时机启动科创板上市计划。
相关推荐
风口上的细胞外囊泡免疫疗法实现临床转化:「盛齐安」DTMI技术湖北多癌种物价获批
细胞外囊泡成疾病治疗新热点,能否开启抗癌新纪元?
创投日报 |「捍宇医疗」获5亿元D轮融资,「中天安驰」获亿元人民币C轮融资;以及今天值得关注的早期项目
瞄准风口上的细胞治疗市场,「赛德特生物」开启全产业链模式
站在基因疗法的风口上
潮科技 | 细胞疗法行业探索:CAPRI细胞疗法
聚焦抗肿瘤创新药,「天科雅」用国际前沿的免疫疗法解决实体瘤难题
本土新药实现出海“零突破”:首款自主研发抗癌新药FDA获批
36氪首发 | 专注新型实体瘤细胞疗法,「君赛生物」获数千万元Pre-A轮融资
融资合伙人入围项目 | 开发创新细胞免疫疗法,「康爱生物」想让细胞治疗更普适、安全、平价
网址: 风口上的细胞外囊泡免疫疗法实现临床转化:「盛齐安」DTMI技术湖北多癌种物价获批 http://www.xishuta.cn/zhidaoview12656.html
推荐专业知识
- 136氪首发 | 瞄准企业“流 3930
- 2失联37天的私募大佬现身,但 3220
- 3是时候看到全球新商业版图了! 2809
- 436氪首发 | 「微脉」获1 2759
- 5流浪地球是大刘在电力系统上班 2708
- 6招商知识:商业市场前期调研及 2698
- 7Grab真开始做财富管理了 2610
- 8中国离硬科幻电影时代还有多远 2328
- 9创投周报 Vol.24 | 2186
- 10微医集团近日完成新一轮股权质 2181
